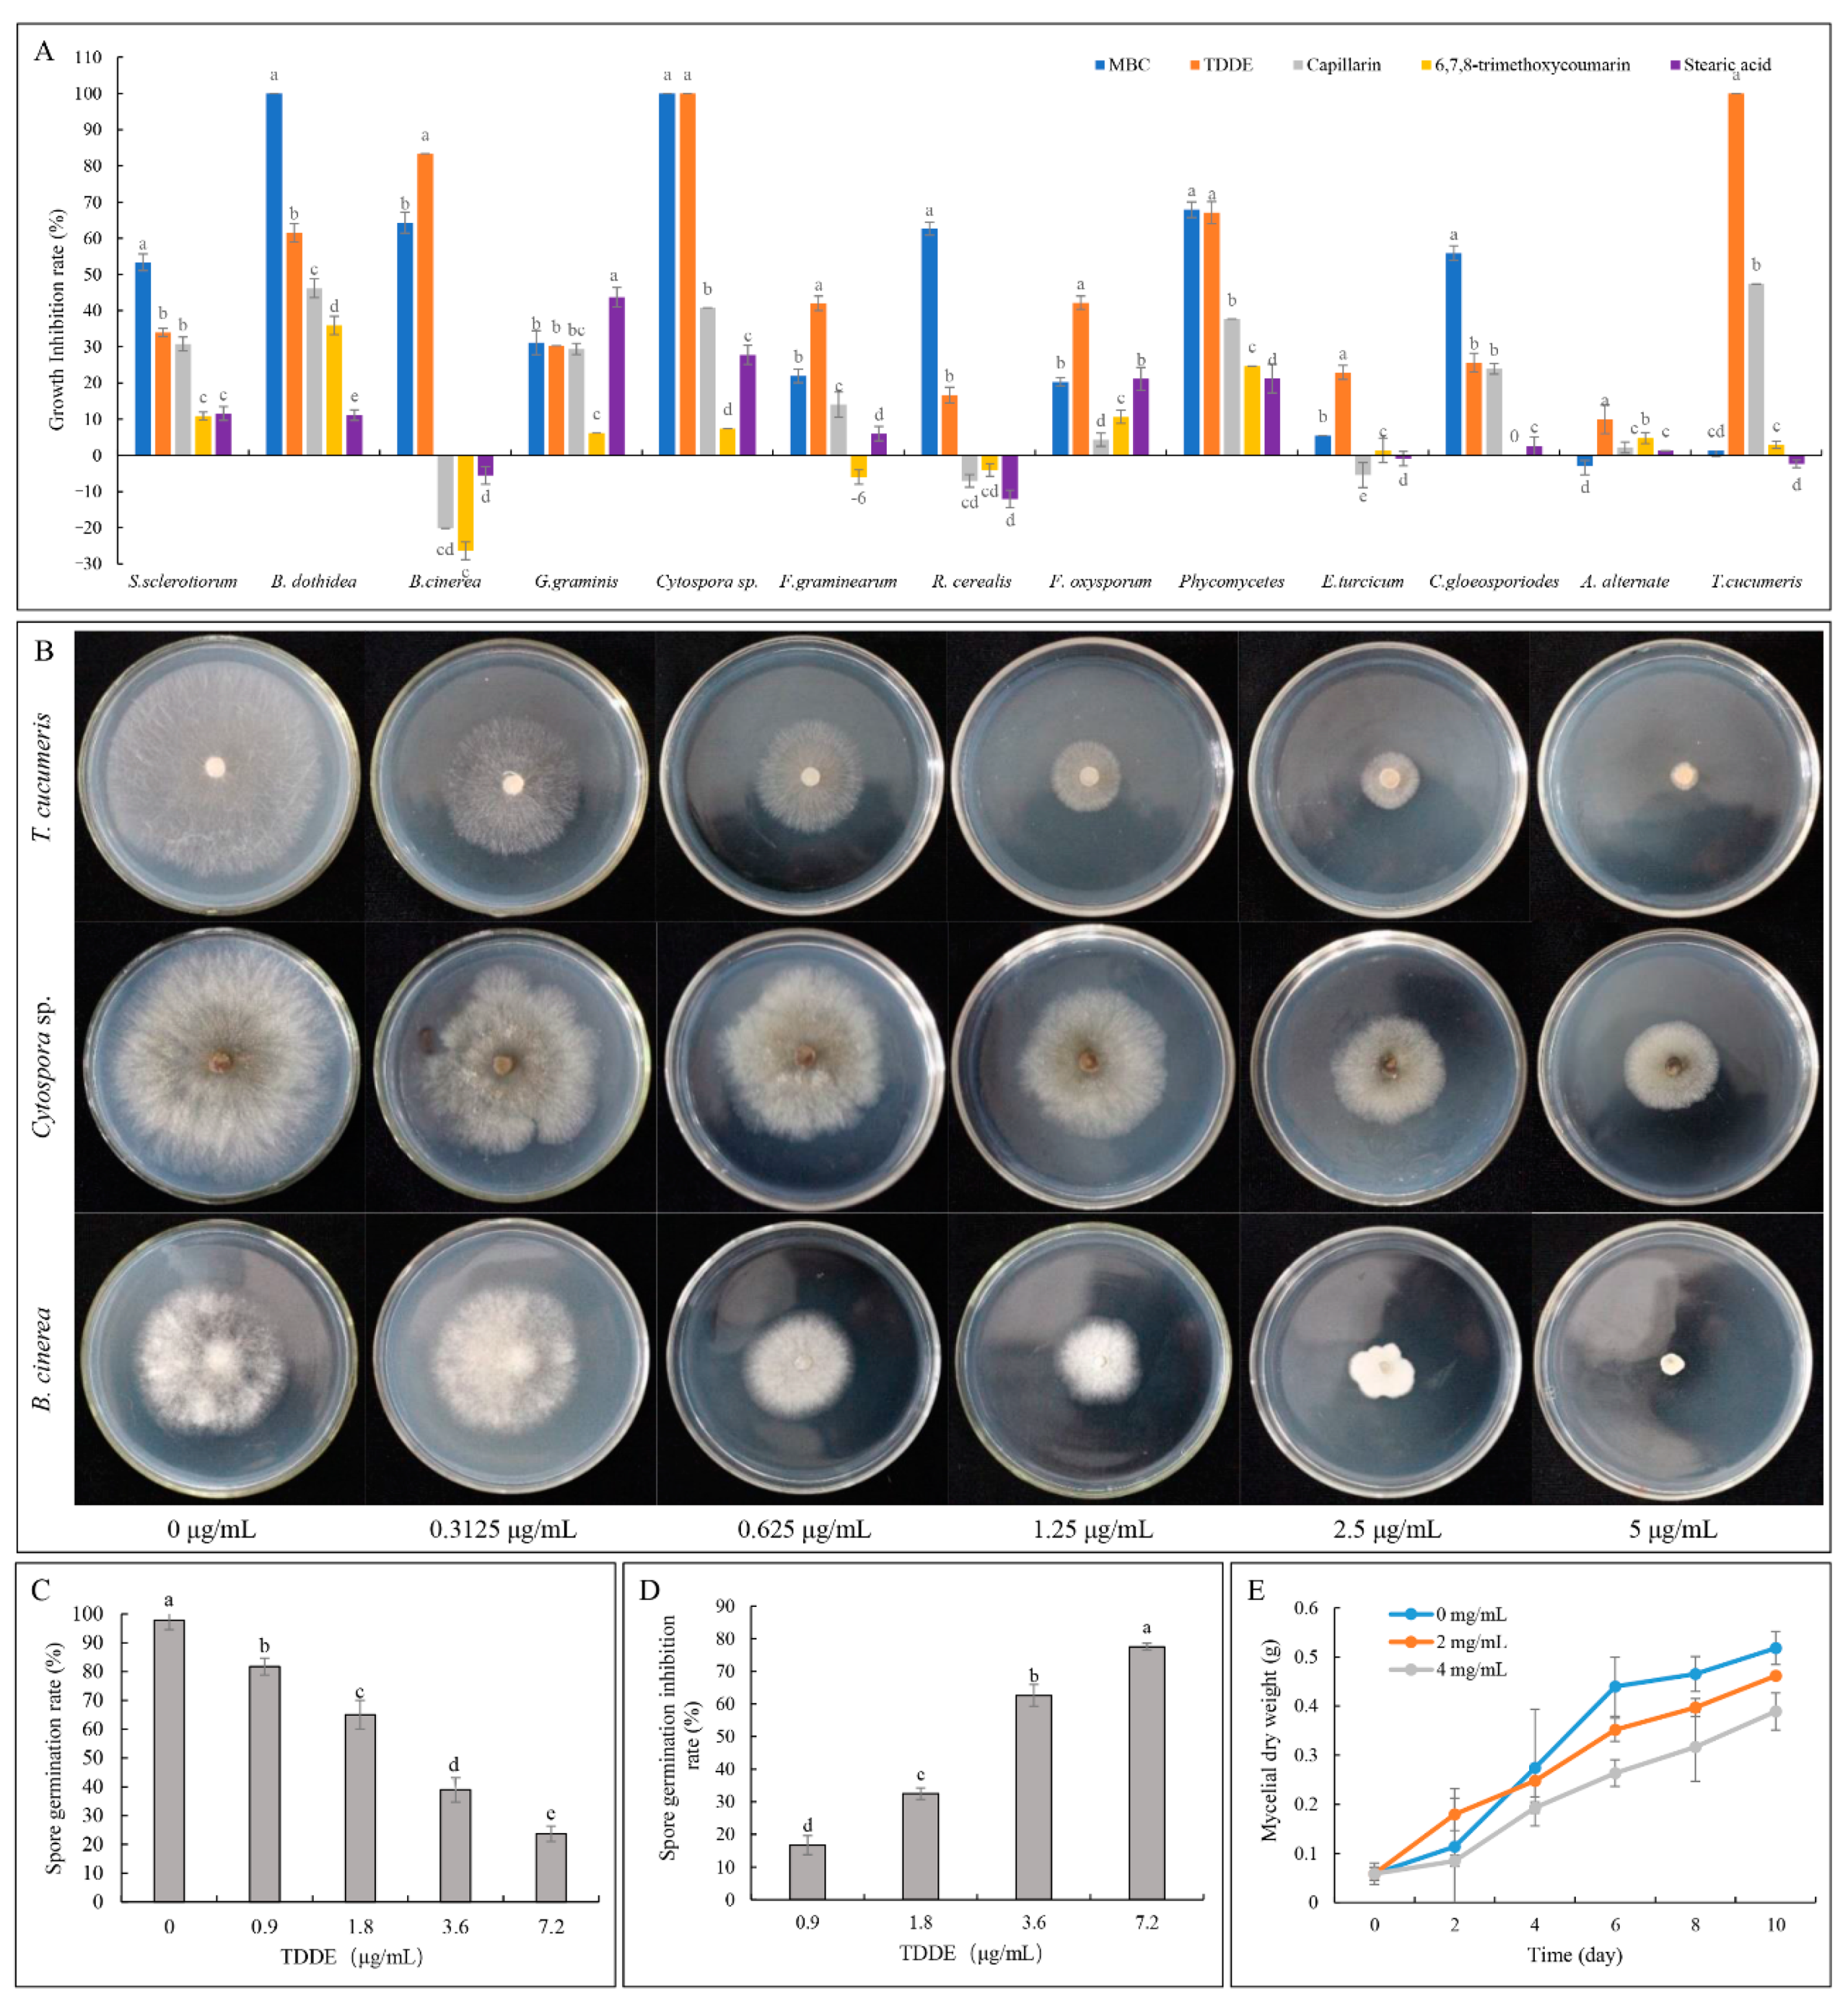

Bioassay-Guided Isolation of Broad-Spectrum Fungicidal Active Compound from Artemisia ordosica
Abstract
1. Introduction
2. Results
2.1. Bioassay-Guided Isolation
2.2. Structural Analysis of Bioactive Compounds
2.3. Antifungal Activity of TDDE (Compound 3) In Vitro and In Vivo
2.3.1. Effect of TDDE on the Mycelial Growth of Different Pathogens
2.3.2. Effect of TDDE on B. cinerea Spore Germination
2.3.3. Effect of TDDE on Detached Plant Tissues Infected with B. cinerea
2.3.4. Effect of TDDE on Tomato and Strawberry Plants Infected with B. cinerea
2.4. Effect of TDDE on the Mycelial Morphology of B. cinerea
2.5. Effect of TDDE on the Physiological Activities of B. cinerea
2.6. Antibacterial Activity of TDDE
3. Discussion
4. Materials and Methods
4.1. Plant Materials and Pathogens
4.1.1. Plant Materials
4.1.2. Pathogens
4.2. Extraction and Isolation of Bioactive Compounds
4.3. Antifungal Activity Assays
4.3.1. Antifungal Activity In Vitro and In Vivo
4.3.2. Effect of Active Compounds on B. cinerea Mycelial Morphology
4.3.3. Effect of Active Compounds on the Physiological Activity of B. cinerea
4.4. Antibacterial Activity Assays
4.4.1. Antibacterial Activity Assay in Culture
4.4.2. Effect of Active Compound on Detached Plant Tissues Infected with Different Pathogenic Bacteria
4.5. Statistical Analysis
5. Conclusions
Supplementary Materials
Author Contributions
Funding
Institutional Review Board Statement
Informed Consent Statement
Data Availability Statement
Conflicts of Interest
References
- Le Dang, Q.; Kim, W.K.; Nguyen, C.M.; Choi, Y.H.; Choi, G.J.; Jang, K.S.; Park, M.S.; Lim, C.H.; Luu, N.H.; Kim, J.-C. Nematicidal and Antifungal Activities of Annonaceous Acetogenins from Annona squamosa against Various Plant Pathogens. J. Agric. Food Chem. 2011, 59, 11160–11167. [Google Scholar] [CrossRef]
- Chen, C.-J.; Li, Q.-Q.; Zeng, Z.-Y.; Duan, S.-S.; Wang, W.; Xu, F.-R.; Cheng, Y.-X.; Dong, X. Efficacy and mechanism of Mentha haplocalyx and Schizonepeta tenuifolia essential oils on the inhibition of Panax notoginseng pathogens. Ind. Crop. Prod. 2020, 145, 112073. [Google Scholar] [CrossRef]
- Laborda, P.; Li, C.; Zhao, Y.; Tang, B.; Ling, J.; He, F.; Liu, F. Antifungal Metabolite p-Aminobenzoic Acid (pABA): Mechanism of Action and Efficacy for the Biocontrol of Pear Bitter Rot Disease. J. Agric. Food Chem. 2019, 67, 2157–2165. [Google Scholar] [CrossRef]
- Kuang, J.; Hou, Y.-P.; Wang, J.-X.; Zhou, M.-G. Sensitivity of Sclerotinia sclerotiorum to fludioxonil: In vitro determination of baseline sensitivity and resistance risk. Crop. Prot. 2011, 30, 876–882. [Google Scholar] [CrossRef]
- Liang, H.-J.; Di, Y.-L.; Li, J.-L.; Zhu, F.-X. Baseline sensitivity and control efficacy of fluazinam against Sclerotinia sclerotiorum. Eur. J. Plant Pathol. 2015, 142, 691–699. [Google Scholar] [CrossRef]
- Ma, H.-X.; Feng, X.-J.; Chen, Y.; Chen, C.-J.; Zhou, M.-G. Occurrence and Characterization of Dimethachlon Insensitivity in Sclerotinia sclerotiorum in Jiangsu Province of China. Plant Dis. 2009, 93, 36–42. [Google Scholar] [CrossRef]
- Yan, H.; Xiong, Z.; Xie, N.; Liu, S.; Zhang, L.; Xu, F.; Guo, W.; Feng, J. Bioassay-guided isolation of antifungal amides against Sclerotinia sclerotiorum from the seeds of Clausena lansium. Ind. Crop. Prod. 2018, 121, 352–359. [Google Scholar] [CrossRef]
- Gao, Y.; Wang, Y.; Li, J.; Shang, S.; Song, Z. Improved application of natural forest product terpene for discovery of potential botanical fungicide. Ind. Crop. Prod. 2018, 126, 103–112. [Google Scholar] [CrossRef]
- Jiang, B.-C.; Shen, J.-Y.; Wu, J.; Lu, R.-Y.; Zheng, W.; Dong, J.-X.; Yan, L.; Jin, Y.-S. In vitro antifungal activity of 163 extracts from traditional Chinese medicine herbs. Eur. J. Integr. Med. 2020, 39, 101213. [Google Scholar] [CrossRef]
- He, X.; Li, Y.; Zhao, L. Dynamics of arbuscular mycorrhizal fungi and glomalin in the rhizosphere of Artemisia ordosica Krasch. in Mu Us sandland, China. Soil Biol. Biochem. 2010, 42, 1313–1319. [Google Scholar] [CrossRef]
- Khurelbat, D.; Densmaa, D.; Sanjjav, T.; Gotov, C.; Kitamura, C.; Shibuya, H.; Ohashi, K. Artemisioside, a new monoterpene glucoside from the aerial parts of Artemisia ordosica (Asteraceae). J. Nat. Med. 2010, 64, 203–205. [Google Scholar] [CrossRef]
- Xiao, B.; Wang, J.-H.; Zhou, C.-Y.; Chen, J.-M.; Zhang, N.; Zhao, N.; Han, X.-Y.; Niu, Y.-X.; Feng, Y.-B.; Du, G.-H. Ethno-medicinal study of Artemisia ordosica Krasch. (traditional Chinese/Mongolian medicine) extracts for the treatment of allergic rhinitis and nasosinusitis. J. Ethnopharmacol. 2019, 248, 112262. [Google Scholar] [CrossRef]
- Wang, J.; Xing, Y.; Jin, X.; Xu, Y.; Shi, B. Active components and antioxidant activity of Artemisa ordosica extracts with different solvents. Anim. Husb. Vet. Med. 2019, 51, 115–120. [Google Scholar]
- Yuanyuan, X.; Yingzhao, W.; Chenyu, M.; Dengsheng, S.; Shiwei, G.; Yuanqing, X.; Xiao, J.; Sumei, Y.; Binlin, S. Water extract of Artemisia ordosica enhances antioxidant capability and immune response without affecting growth performance in weanling piglets. J. Anim. Physiol. Anim. Nutr. 2019, 103, 1848–1856. [Google Scholar]
- Xiao, B.; Bai, J.; Qi, L.; Lu, L.; Tian, X.; Yin, J.; Su, Y. Research progress of resource distribution, chemical component and pharmacological activity in Artemisia ordosica. China Pharm. 2016, 27, 1862–1864. [Google Scholar]
- Zhao, D.-B.; Yang, Y.-X.; Zhang, W.; Liu, X.-H.; Wang, H.-Q. Studies on flavonoids from herb of Artemisia ordosica. China J. Chin. Mater. Med. 2005, 30, 1430–1432. [Google Scholar]
- Wang, Q.; Pa, B.; Gong, J.; Bao, W.; Hao, J.; Xu, Y. Phenylpropanoids, flavonoids, and terpenoids from Artemisia ordosica Krasch. Magn. Reson. Chem. 2019, 57, 326–330. [Google Scholar] [CrossRef] [PubMed]
- Basenjirigala; Wang, Q.; Hao, J.; Gong, J.; Bao, W. Biligetu, Qualitative Analysis of Volatile Oil from Artemisia ordosica Krasch by GC-MS. J. Inn. Mong. Univ. Natl. 2019, 34, 87–92. [Google Scholar]
- Tan, R.X.; Zheng, W.F.; Tang, H.Q. Biologically active sub-stances from the genus Artemisia. Planta Med. 1998, 64, 295. [Google Scholar] [CrossRef]
- Zhao, D.B.; Jiang, Y.F.; Xi, C.J.; Liu, X.H.; Wang, H.Q. Isolation and identification of capillarin from Artemisia ordosica Kraschen. Chin. J. Struct. Chem. 2005, 24, 637–640. [Google Scholar]
- Wang, Q.-H.; Gong, J.-H.; Hao, J.-S.; Xu, Y.-H. Structure Elucidation of a New Lignan Glycoside from Artemisia ordosica. Chem. Nat. Compd. 2019, 55, 1007–1009. [Google Scholar] [CrossRef]
- Bao, W.; Wang, Q.; Hao, J. Structural Elucidation of a Coumarin with New Skeleton from Artemisia ordosica. Rec. Nat. Prod. 2019, 13, 413–417. [Google Scholar] [CrossRef]
- Wu, G.-H.; Wang, Q.-H.; He, X.; Bao, W.-Q.; Pa, B.-L. Structural elucidation of two new compounds from Artemisia ordosica and their antioxidative activity. J. Chem. Sci. 2019, 74, 699–702. [Google Scholar] [CrossRef]
- Wang, Q.; Hao, J.; Gong, J.; Bao, W. Isolation and structure elucidation of two new compounds from Artemisia ordosica Krasch. Nat. Prod. Res. 2020, 34, 1862–1867. [Google Scholar] [CrossRef]
- Zhang, Z.; Guo, S.-S.; Zhang, W.-J.; Geng, Z.-F.; Liang, J.-Y.; Du, S.-S.; Wang, C.-F.; Deng, Z.-W. Essential oil and polyacetylenes from Artemisia ordosica and their bioactivities against Tribolium castaneum Herbst (Coleoptera: Tenebrionidae). Ind. Crop. Prod. 2017, 100, 132–137. [Google Scholar] [CrossRef]
- Kai, K.; Hua, C.; Sui, Y.; Bi, W.; Shi, W.; Zhang, D.; Ye, Y. Curcumin triggers the immunity response in kiwifruit against Botrytis cinerea. Sci. Hortic. 2020, 274, 109685. [Google Scholar] [CrossRef]
- Yu, Z.; Han, L.; Wu, H.; Feng, J.; Zhang, X. Preliminary fungistasis screening of 34 plants extracts. J. Northwest Agric. For. Univ. 2012, 40, 72–76. [Google Scholar]
- Veloso, P.A.; Pimenta, A.T.; Falcão, M.J.; Gramosa, N.V.; Silva Junior, J.N.; Silveira, E.R.; Lima, M.A. New flavonoids and coumarins from Platymiscium floribundum Vogel. J. Braz. Chem. Soc. 2012, 23, 1239–1243. [Google Scholar] [CrossRef][Green Version]
- Tong, Q.; Wang, Q.; Pa, B.; Bao, W.; Hao, J. Two new compounds from Artemisia ordosica Krasch. Nat. Prod. Res. 2020, 34, 3061–3065. [Google Scholar] [CrossRef] [PubMed]
- Lin, M.; Zhang, W.; Su, J. Toxic polyacetylenes in the genus Bupleurum (Apiaceae) Distribution, toxicity, molecular mechanism and analysis. J. Ethnopharmacol. 2016, 193, 566–573. [Google Scholar] [CrossRef]
- Plesken, C.; Pattar, P.; Reiss, B.; Noor, Z.N.; Zhang, L.; Klug, K.; Huettel, B.; Hahn, M. Genetic Diversity of Botrytis cinerea Revealed by Multilocus Sequencing, and Identification of B. cinerea Populations Showing Genetic Isolation and Distinct Host Adaptation. Front. Plant Sci. 2021, 12, 663027. [Google Scholar] [CrossRef]
- Sernaite, L.; Rasiukeviciute, N.; Valiuskaite, A. Application of Plant Extracts to Control Postharvest Gray Mold and Susceptibility of Apple Fruits to B. cinerea from Different Plant Hosts. Foods 2020, 9, 1430. [Google Scholar] [CrossRef] [PubMed]
- Fang, X.; Zhang, M.; Tang, Q.; Wang, Y.; Zhang, X. Inhibitory effect of Xenorhabdus nematophila TB on plant pathogens Phytophthora capsici and Botrytis cinerea in vitro and in planta. Sci. Rep. 2014, 4, 1–7. [Google Scholar]
- Fang, X.; Li, Z.; Wang, Y.; Zhang, X. In vitro and in vivo antimicrobial activity of Xenorhabdus bovienii YL002 against Phytophthora capsici and Botrytis cinerea. J. Appl. Microbiol. 2011, 111, 145–154. [Google Scholar] [CrossRef]
- Gasparotto, L.; Kano, C.; Ceresini, P.; Pereira, J.; Cardoso, M.; Pereira, D.; Castroagudín, V.L. Web blight (Thanatephorus cucumeris): A new disease on leaves of okra plants. Arq. Inst. Biol. Sao Paulo 2017, 84. [Google Scholar] [CrossRef]
- Pourmahdi, A.; Taheri, P. Genetic Diversity of Thanatephorus cucumeris Infecting Tomato in Iran. J. Phytopathol. 2014, 163, 19–32. [Google Scholar] [CrossRef]
- González, N.; Godoy-Lutz, G.; Steadman, J.R.; Higgins, R.; Eskridge, K.M. Assessing genetic diversity in the web blight pathogen Thanatephorus cucumeris (anamorph Rhizoctonia solani) subgroups AG-1-IE and AG-1-IF with molecular markers. J. Gen. Plant. Pathol. 2012, 78, 85–98. [Google Scholar] [CrossRef]
- Ji, Z.; Liu, F.; Zhang, Z.; Li, F.; Jiang, L. Synthesis and Antifungal Activity of Novel 2-(1H-Benzimidazol-2-yl)-5-substituted-1,3,4-oxadiazole Derivatives. Chin. J. Org. Chem. 2012, 32, 2129. [Google Scholar] [CrossRef][Green Version]
- He, L.; Liu, H.F.; Htun, A.A.; Ge, H.; Deng, J.X.; Du, T. First Report of Alternaria cinerariae Causing Leaf Spot on Tussilago farfara in China. Plant. Dis. 2020, 104, 3264. [Google Scholar] [CrossRef]
- He, H.; Hao, X.; Zhou, W.; Shi, N.; Feng, J.; Han, L. Identification of antimicrobial metabolites produced by a potential biocontrol Actinomycete strain A217. J. Appl. Microbiol. 2019, 128, 1143–1152. [Google Scholar] [CrossRef] [PubMed]
- Sampietro, D.A.; Sampietro, M.S.B.; Vattuone, M.A. Efficacy of Argentinean propolis extracts on control of potato soft rot caused by Erwinia carotovora subsp. J. Sci. Food Agric. 2020, 100, 4575–4582. [Google Scholar] [CrossRef] [PubMed]
- Guo, Z.; Wang, Q. Efficacy of Ozonated Water Against Erwinia carotovora subsp carotovora in Brassica campestris ssp chinensis. Ozone Sci. Eng. 2017, 39, 127–136. [Google Scholar] [CrossRef]
- Cellini, A.; Donati, I.; Farneti, B.; Khomenko, I.; Buriani, G.; Biasioli, F.; Cristescu, S.M.; Spinelli, F. A Breach in Plant Defences: Pseudomonas syringae pv. actinidiae Targets Ethylene Signalling to Overcome Actinidia chinensis Pathogen Responses. Int. J. Mol. Sci. 2021, 22, 4375. [Google Scholar] [CrossRef]
- Konovalov, D. Polyacetylene Compounds of Plants of the Asteraceae Family (Review). Pharm. Chem. J. 2014, 48, 613–631. [Google Scholar] [CrossRef]
- Resetar, M.; Liu, X.; Herdlinger, S.; Kunert, O.; Pferschy-Wenzig, E.-M.; Latkolik, S.; Steinacher, T.; Schuster, D.; Bauer, R.; Dirsch, V.M. Polyacetylenes from Oplopanax horridus and Panax ginseng: Relationship between Structure and PPAR gamma Activation. J. Nat. Prod. 2020, 83, 918–926. [Google Scholar] [CrossRef]
- Dawid, C.; Dunemann, F.; Schwab, W.; Nothnagel, T.; Hofmann, T. Bioactive C-17-Polyacetylenes in Carrots (Daucus carota L.): Current Knowledge and Future Perspectives. J. Agric. Food Chem. 2015, 63, 9211–9222. [Google Scholar] [CrossRef] [PubMed]
- Xu, W.-J.; Li, J.-H.; Zhou, M.-M.; Luo, J.; Jian, K.-L.; Tian, X.-M.; Xia, Y.-Z.; Yang, L.; Luo, J.; Kong, L.-Y. Toonasindiynes A-F, new polyacetylenes from Toona sinensis with cytotoxic and anti-inflammatory activities. Fitoterapia 2020, 146, 104667. [Google Scholar] [CrossRef] [PubMed]
- Zhang, S.; Liu, Q.; Han, Y.; Han, J.; Yan, Z.; Wang, Y.; Zhang, X. Nematophin, an Antimicrobial Dipeptide Compound from Xenorhabdus nematophila YL001 as a Potent Biopesticide for Rhizoctonia solani Control. Front. Microbiol. 2019, 10, 1765. [Google Scholar] [CrossRef]
- Lyu, A.; Liu, H.; Che, H.; Yang, L.; Zhang, J.; Wu, M.; Chen, W.; Li, G. Reveromycins A and B from Streptomyces sp. 3–10: Antifungal Activity against Plant Pathogenic Fungi In vitro and in a Strawberry Food Model System. Front. Microbiol. 2017, 8, 550. [Google Scholar] [CrossRef]
- Wang, Y.; Duan, Y.-B.; Zhou, M.-G. Baseline sensitivity and efficacy of fluazinam in controlling Sclerotinia stem rot of rapeseed. Eur. J. Plant Pathol. 2015, 144, 337–343. [Google Scholar] [CrossRef]
- Wang, Y.; Sun, Y.; Zhang, Y.; Zhang, Y.; Han, L.; Zhang, X.; Feng, J. Sensitivity and biochemical characteristics of Sclerotinia sclerotiorum to propamidine. Biochem. Physiol. 2017, 135, 82. [Google Scholar] [CrossRef] [PubMed]
- Yang, Q.; Wang, J.; Zhang, P.; Xie, S.; Yuan, X.; Hou, X.; Yan, N.; Fang, Y.; Du, Y. In vitro and in vivo antifungal activity and preliminary mechanism of cembratrien-diols against Botrytis cinerea. Ind. Crop. Prod. 2020, 154, 112745. [Google Scholar] [CrossRef]
- Ali, G.S.; Reddy, A.S.N. Inhibition of Fungal and Bacterial Plant Pathogens by Synthetic Peptides: In Vitro Growth Inhibition, Interaction Between Peptides and Inhibition of Disease Progression. Mol. Plant Microbe Interact. 2000, 13, 847–859. [Google Scholar] [CrossRef] [PubMed]

| Fungus Name | Toxicity Regression Equation | EC50 Confidence Interval (μg/mL) | R2 | χ2 |
|---|---|---|---|---|
| A. alternate | Y = 2.538X − 7.153 | 658.462 (509.233 − 030.727) f | 0.969 | 1.633 |
| B. dothidea | Y = 1.371X − 2.559 | 73.443 (60.976 − 134.885) a | 0.966 | 0.820 |
| B.cinerea | Y = 4.669X − 12.425 | 458.382 (408.158 − 547.635) e | 0.986 | 0.671 |
| T. cucumeris | Y = 1.843X − 3.455 | 75.007 (46.654 − 98.101) a | 0.973 | 1.115 |
| S. sclerotiorum | Y = 3.276X − 7.533 | 199.276 (180.175 − 220.361) cd | 0.939 | 8.002 |
| F. graminearum | Y = 2.484X − 5.773 | 210.765 (185.416 − 240.740) | 0.953 | 3.873 |
| R. cerealis | Y = 7.028X − 15.922 | 184.338 (139.056 − 240.433) c | 0.946 | 19.642 |
| G. graminis | Y = 4.541X − 9.172 | 104.678 (77.664 − 126.254) b | 0.906 | 21.455 |
| E.turcicum | Y = 1.154X − 3.287 | 703.142 (444.042 − 2397.242) g | 0.947 | 0.911 |
| Cytospora sp. | Y =7.123X − 16.824 | 230.157 (215.675 − 245.254) d | 0.990 | 1.714 |
| Fungus Name | Toxicity Regression Equation | EC50 Confidence Interval (µg/mL) | R2 | χ2 |
|---|---|---|---|---|
| Cytospora sp. | Y = 1.734 − 0.409X | 1.722(1.466 − 2.019) e | 0.952 | 10.25 |
| B. cinerea | Y = 2.95 − 0.432X | 1.401(1.259 − 1.544) c | 0.997 | 0.709 |
| T. cucumeris | Y = 0.724 + 2.175X | 0.464(0.391 − 0.537) a | 0.974 | 11.684 |
| B. dothidea | Y = 3.33X − 2.427 | 5.33(4.281 − 6.585) d | 0.977 | 59.627 |
| R. cerealis | Y = 0.144 + 1.729X | 0.826(0.702 − 0.956) b | 0.978 | 8.193 |
| G. graminis | Y = 3.710X − 3.969 | 11.741 (8.361 − 17.123) f | 0.96 | 66.287 |
Publisher’s Note: MDPI stays neutral with regard to jurisdictional claims in published maps and institutional affiliations. |
© 2021 by the authors. Licensee MDPI, Basel, Switzerland. This article is an open access article distributed under the terms and conditions of the Creative Commons Attribution (CC BY) license (https://creativecommons.org/licenses/by/4.0/).
Share and Cite
Tang, G.; Yang, S.; Hu, W.; Jiang, J.; Yan, H.; Feng, J.; Zhang, C.; Wang, Y. Bioassay-Guided Isolation of Broad-Spectrum Fungicidal Active Compound from Artemisia ordosica. Metabolites 2021, 11, 629. https://doi.org/10.3390/metabo11090629
Tang G, Yang S, Hu W, Jiang J, Yan H, Feng J, Zhang C, Wang Y. Bioassay-Guided Isolation of Broad-Spectrum Fungicidal Active Compound from Artemisia ordosica. Metabolites. 2021; 11(9):629. https://doi.org/10.3390/metabo11090629
Chicago/Turabian StyleTang, Gaijuan, Shuyu Yang, Wenqiong Hu, Jingyi Jiang, He Yan, Juntao Feng, Chao Zhang, and Yonghong Wang. 2021. "Bioassay-Guided Isolation of Broad-Spectrum Fungicidal Active Compound from Artemisia ordosica" Metabolites 11, no. 9: 629. https://doi.org/10.3390/metabo11090629
APA StyleTang, G., Yang, S., Hu, W., Jiang, J., Yan, H., Feng, J., Zhang, C., & Wang, Y. (2021). Bioassay-Guided Isolation of Broad-Spectrum Fungicidal Active Compound from Artemisia ordosica. Metabolites, 11(9), 629. https://doi.org/10.3390/metabo11090629

